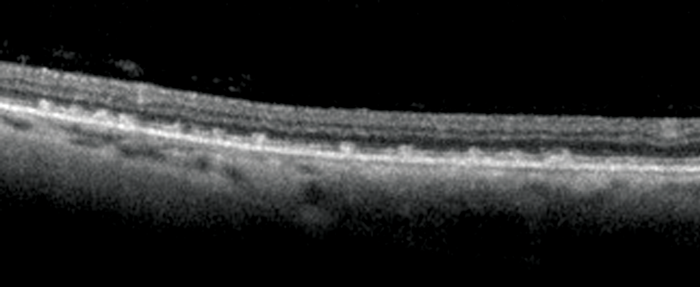

History
A 65-year-old lady presented with a ten year history of nonspecific visual disturbance and mild symptoms of dry eyes. Questioning revealed progressive nyctalopia. Previous medical history of note included Crohn’s disease requiring two bowel resections including small intestine.

Figure 1a: Right eye anterior segment.

Figure 1b: Left eye anterior segment.
Figure 2: Left OCT of temporal retina.

Figure 3a.

Figure 3b
Figure 3a and 3b: Left colour image of macular and mid temporal
periphery (note flash artefact upper right of both images).
Questions
1. What clinical sign is present in Figure 1a and b? What does the optical coherence tomography (OCT) in Figure 2 show and what clinical features can be seen in Figure 3?
2. What are the diagnosis, clinical features and associations of this condition?
3. What investigations are needed?
4. What is the treatment?
Answers
1. Figures 1a and 1b exhibit Bitot spots. These are either dry or foamy greasy triangular excrescences of superficial intrapalpebral conjunctiva and represent keratinising epithelium. The foamy type is often associated with gas producing organism Corynebacterium xerosis. Figure 2 shows an OCT section with multiple excrescences at the level of the retinal pigment epithelium corresponding to the white dots seen in Figure 3. Figure 3 shows multiple, fine subretinal punctate white dots in the fundus. This is best seen in Figure 3b in which the white dots are seen contrasted against the background of a pigmented choroidal naevus. The dots can often resemble fundus albipunctatus.
2. Diagnosis: Vitamin A deficiency. Presents with nyctalopia, dry eyes with conjunctival and corneal xerosis, corneal ulceration and rarely keratomalacia as sequlae. Vitamin A is required for conjunctival and corneal epithelial maintenance, retinal photo transduction and retinal pigment cell viability Associations:
- Poor dietary intake
- Decreased intestinal absorption (e.g. after surgery for Crohn’s)
- Defective transportation or liver disease
- Post-surgery for morbid obesity - incidence of vitamin A deficiency after biliopancreatic surgery varies from 10% to 69% and several case reports have noted night blindness and other visual complications associated with vitamin A deficiency after bariatric surgery (Scopinaro’s operation).
3. Investigations should include:
- Serological analysis of vitamin A, and other fat soluble vitamins E and D. This patient’s presenting vitamin A level was 0.26µmol/L (normal 1.1-2.6), vitamin E was 2.87µmol/L (normal 11-47).
- Electrophysiology studies. These show reduced rod and cone function which is reversible with treatment.
4. Treat the cause. Vitamin A supplementation orally or intramuscular injection (100,000 units/2ml). This patient was given oral supplementation Vitamin A and D, Halibut liver oil capsules 4,000 units OD with improvement of her symptoms, normalisation of her electro-diagnostic tests, resolution of her Bitot’s spots and fundal white dots. Lubricant drops can also be prescribed for symptomatic relief of dry eyes.
COMMENTS ARE WELCOME


